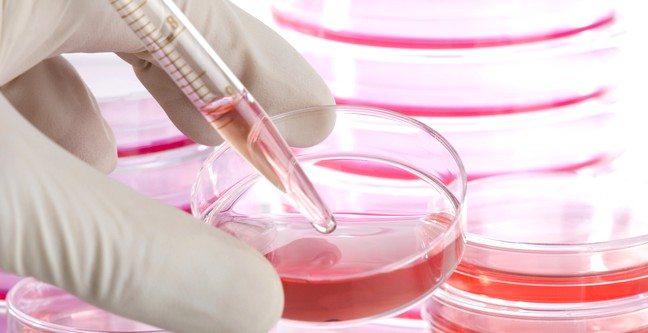
kok-hucre-lab-deney

Parkinson tedavisinde ‘çığır açan’ kök hücre araştırması heyecan yarattı
 İsveçli bilim insanlarına göre, kök hücreler Parkinson hastalığının beyinde yarattığı hasarı iyileştirebilir. Araştırma kapsamında Parkinson’un tedavisiyle ilgili bir araştırma için sıçanların beyinleri üzerinde deneyler yapıldı. Araştırmacılar, sonuçların Parkinson hastalığının tedavisinde etkili olabilecek büyük bir buluş olduğu görüşünde. Hastalığın çaresi henüz bulunamadı; ancak ilaç desteği ve beyin uyarımı tedavisiyle hastalığın semptomları hafifletilebiliyor.
İsveçli bilim insanlarına göre, kök hücreler Parkinson hastalığının beyinde yarattığı hasarı iyileştirebilir. Araştırma kapsamında Parkinson’un tedavisiyle ilgili bir araştırma için sıçanların beyinleri üzerinde deneyler yapıldı. Araştırmacılar, sonuçların Parkinson hastalığının tedavisinde etkili olabilecek büyük bir buluş olduğu görüşünde. Hastalığın çaresi henüz bulunamadı; ancak ilaç desteği ve beyin uyarımı tedavisiyle hastalığın semptomları hafifletilebiliyor.
Parkinson, beyindeki dopamin adlı kimyasalı üreten sinir hücrelerinin hasara uğraması ve kaybedilmesinden kaynaklanan önemli bir rahatsızlık. Dopamin, kişinin ruh hali ve hareketlerini kontrol etme görevi görüyor. Lund Üniversitesi araştırmacıları, Parkinson semptomlarını sıçanlarda canlandırmak amacıyla, sıçanların beyinlerinin tek bir tarafındaki dopamin üreten nöronları öldürdü. Ardından, insandaki gelişmemiş kök hücrelerini dopamin üreten nöronlara dönüştürdü. Bu nöronlar, sıçanların beyinlerine enjekte edildi ve araştırmacılar beyindeki hasarın iyileştiğini gözlemledi.
Kök hücreden türeyen nöronlar henüz insanlar üstünde test edilmedi. Ancak araştırma ekibi insanlar üzerinde test yapmak için 2017’de hazır olabileceklerini söyledi. Gelişimsel ve Rejeneratif Nörobiyoloji Bölümü’nden Doç. Malin Parmar, araştırmayı “Bu alanda yapılmış büyük bir buluş ve klinik testler için bir atlama taşı” olarak değerlendirdi.
Daha önce fetuslar da kullanılmıştı
Buna benzer bir yöntemle daha önce de az sayıda hasta üstünde testler yapılmıştı.
Bu deneylerde araştırmacılar beyni iyileştirme amacıyla, düşük vakalarındaki fetuslardan alınan (fötal) beyin dokularını kullanmıştı. Yapılan klinik denemeler sonucunda bazı karışık sonuçlara ulaşılmış ve testler yarıda bırakılmıştı. Fakat teste tabi tutulan bu hastaların yaklaşık üçünün fötal beyin hücreleri 25 yıl fonksiyonlarını devam ettirmişti.
Embriyonik kök hücreleri daha tercih edilebilir bir yöntem sayılıyor, çünkü nakil için gereken çok sayıda hücreyi üreterek ve çoğaltarak onları laboratuarda tutmak daha kolay bulunuyor. Ayrıca bu yöntemle, yetişkin dokularından yapılan nakillerde olduğu gibi etik olarak tartışmalı kök hücresi kaynakları kullanılmamış oluyor.
İngiltere’deki yardım derneği Parkinson’s UK, araştırmanın “parkinsonlu hastalar üzerinde yapılan klinik testler açısından büyük bir aşama” olduğunu ifade etti. Projenin araştırma ve geliştirme yöneticisi Arthur Roach yaptığı açıklamada, “Bu önemli araştırma, kök hücrelerinin Parkinson’un geleceğini nasıl değiştirebileceğini anlayabilmemiz açısından anahtar değerinde. Kök hücrelerinin, eskiden nakillerde kullanılmış fötal kökenli hücreler üzerinde çok önemli olası avantajları var” şeklinde konuştu.

Parkinson’s UK adlı yardım derneği, bu bulgular insanlar üstünden test edilmeden önce cevaplanması gereken bir çok soru olduğunu söyledi.BBC
YAZIYI PAYLAŞ

İsveçli bilim insanlarına göre, kök hücreler Parkinson hastalığının beyinde yarattığı hasarı iyileştirebilir. Araştırma kapsamında Parkinson’un tedavisiyle ilgili bir araştırma için sıçanların beyinleri üzerinde deneyler yapıldı. Araştırmacılar, sonuçların Parkinson hastalığının tedavisinde etkili olabilecek büyük bir buluş olduğu görüşünde. Hastalığın çaresi henüz bulunamadı; ancak ilaç desteği ve beyin uyarımı tedavisiyle hastalığın semptomları hafifletilebiliyor.
İsveçli bilim insanlarına göre, kök hücreler Parkinson hastalığının beyinde yarattığı hasarı iyileştirebilir. Araştırma kapsamında Parkinson’un tedavisiyle ilgili bir araştırma için sıçanların beyinleri üzerinde deneyler yapıldı. Araştırmacılar, sonuçların Parkinson hastalığının tedavisinde etkili olabilecek büyük bir buluş olduğu görüşünde. Hastalığın çaresi henüz bulunamadı; ancak ilaç desteği ve beyin uyarımı tedavisiyle hastalığın semptomları hafifletilebiliyor. Dopamin nedir? Ne işe yarar? Eksikliği ne tür sorunlar yaratır?
Dopamin nedir? Ne işe yarar? Eksikliği ne tür sorunlar yaratır? Kök hücre nedir? Kök hücre tedavisi ne işe yarar? Nakli nasıl yapılır?
Kök hücre nedir? Kök hücre tedavisi ne işe yarar? Nakli nasıl yapılır? Parkinson tedavisi: En etkili yöntemler ve hastalara öneriler
Parkinson tedavisi: En etkili yöntemler ve hastalara öneriler Parkinson hastalığı neden olur? Belirtileri ve tedavisi
Parkinson hastalığı neden olur? Belirtileri ve tedavisi Parkinson hastalığı neden olur? Belirtileri, teşhisi ve evreleri
Parkinson hastalığı neden olur? Belirtileri, teşhisi ve evreleri
YORUMUNUZ VAR MI?